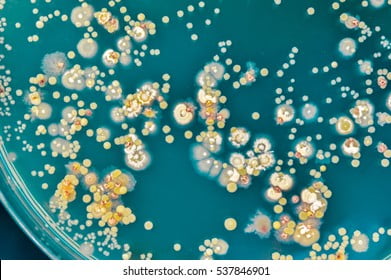

(এই শিরোনামে জীববিজ্ঞানের কিছু সহজ পরীক্ষা যেগুলো আমাদের দেশের সাধারন পরীক্ষাগারেই করতে পারি তার প্রক্রিয়াগুলি তুলে ধরছি।)
ব্যাকটেরিয়া চাষ করতে চান ঘরেই? কালচার মিডিয়া বা ব্যাকটেরিয়া খুঁজে পাচ্ছেন না? কোন ব্যাপারই না। দেখে নিন কিভাবে করবেন।
কি কি লাগবেঃ
১। জিলাটিন বা আগার আগার পাউডার। এদেরকে গরম দ্রবণ তৈরি করলে ঠান্ডা করার পর জেলির মত হয়। কত শক্ত জেলি হবে সেটা নির্ভর করবে কতটুকু পাউডারে কতটুকু পানি দেবেন তার উপর। জিলাটিন পশুর দেহ থেকে বানানো হয়, সেজন্য প্রাণীজ। আগার আগার রেড এলজি থেকে, সেজন্য উদ্ভিজ্জ। যেকোন একটা ব্যবহার করতে পারেন। দেশের কিছু খাবারের দোকানে এগুলো পাওয়া যাবে। হয়তো কারো রান্নাঘরেই পেয়ে যাবেন।
২। গরুর মাংস এক টুকরা, ৩ ইঞ্চির কিউব হলে হবে। এখানে লক্ষ্য করবেন, মাংস লাগবে শুধু যদি আগার আগার ব্যবহার করেন। কিন্তু জিলাটিন ব্যবহার করলে দরকার হবেনা।
৩। চিনি
৪। লবণ
৫। পাত্র যেটা চুলায় বা অন্যভাবে গরম করা যাবে। কাঁচের হলে ভাল হয়। ভালভাবে ঢাকনা দেয়া যায় এমন পাত্র হতে হবে। বয়াম টাইপের কিছু হলে সবচেয়ে ভাল।
৬। ছোট পাতিল

কিভাবে করবেনঃ
কালচার মিডিয়া তৈরি>
১। একটা ছোট পাতিলে গরুর মাংস নিয়ে উপরে অল্প পানি ঢেলে গরম করুন। পানি ফুটন্ত অবস্থায় ১০ মিনিট রেখে দিন। টুকরাটি কিছু দিয়ে একটু চেপে বা নেড়ে দিন। পানিটুকু সংগ্রহ করুন কিছুতে। মাংসের টুকরাটি আর লাগবেনা। যেই পানিটুকু পেলেন এটা হল বিফ ব্রথ।
৩। এবার একটি পাতিলে (আগের পাতিলটিও চাইলে ব্যবহার করতে পারেন) খানিকটা পানি ঢালুন। (বি.দ্র. কতটুকু পানি ঢালবেন সেটা এগার এগার এর প্যাকেটের নির্দেশনা থেকে দেখে নিন। আমাদের একটি শক্ত জেলির মত বস্তু তৈরি করতে হবে। সেজন্য যতটুকু দিতে বলা হয়েছে তার চেয়ে একটু বেশি পাউডার দেবেন বা কম পানি দেবেন। দরকার হলে আগেই পাউডার আর পানির কয়েকটি অনুপাত পরীক্ষা করে দেখতে পারেন কোনটাতে শক্ত জেলি তৈরি হয়। )
৪। পানি চুলায় গরম করুন। ফুটতে শুরু করলে তাতে এক টেবিল চামচ প্রস্তুতকৃত ব্রথ, এগার এগার পাউডার, এক ছোট চামচ চিনি এবং এক চিমটি লবণ ঢেলে গুলিয়ে নিন। ঢাকনা দিয়ে ১৫ মিনিট ফুটন্ত অবস্থায় রাখুন। এবারে পাতিলটি নামিয়ে ঠান্ডা হতে দিন।
৫। আরেকটি ছোট পাত্র/ বয়াম চুলার উপর ঢাকনা দিয়ে রেখে গরম করে নিন ভালভাবে। ১৫ মিনিট উচ্চতাপে রেখে দেবেন। মনে রাখবেন পাত্রের ঢাকনা আলতো ভাবে লাগাবেন।
৬। গরম হয়ে গেলে পাতিলের আগার দ্রবণটি এই বয়াম/ পাত্রে ঢেলে রেফ্রিজারেটরে রেখে দিন।
৭। পরের দিন সকাল বেলা বের করুন। শক্ত জেলির মত মিডিয়া দেখতে পাবেন। হয়ে গেল কালচার মিডিয়া তৈরি।
ব্যাকটেরিয়া চাষ>
৮। চুলা জ্বালিয়ে তার পাশে কালচার মিডিয়ার ঢাকনাটি খুলুন।
৯। এবার আপনার বুড়া আঙুলটি শক্ত আগার বা জিলাটিনের উপর স্পর্শ করে আলতো করে ঢাকনা লাগিয়ে দিন। পাত্রটি ছায়াযুক্ত কিন্তু একটু গরম যায়গায় রেখে দিন।
১০। দুই দিন পর দেখুন যেখানে স্পর্শ করেছেন সেখানো ছোট ছোট বিন্দুর মত কিছু তৈরি হয়েছে কিনা। যদি দেখেন তৈরি হয়েছে তবে বুঝবেন এটা আপনার হাতের ব্যাকটেরিয়া। যদি তৈরি না হয় তবে বুঝবেন আপনি খুব ভাল করে হাত ধুয়েছিলেন স্পশর্ করার আগে! তাই কোন ব্যাকটেরিয়া নাই।
সতর্কতাঃ
১। ব্যাকটেরিয়ার কালচারটি যেনতেন জায়গায় ফেলে রাখবেন না। শক্ত জেলিটি হয় মাটির নিচে পূঁতে ফেলুন বা ফুটন্ত পানিতে ১ ঘন্টা গরম করে ময়লার ড্রেনে ছেড়ে দিন। হাত ভালভাবে সাবান দিয়ে ধুয়ে ফেলতে ভুলবেন না।
২। সম্ভব হলে মাইক্রোবায়োলজি পরীক্ষার সতর্কতা পদ্ধতিগুলো শিখে ফেলুন। বেশিরভাগ ব্যাকটেরিয়া মানুষের জন্য ক্ষতিকর না, কিন্তু কিছু কিছু ক্ষতিকর।
কিভাবে কাজ করেঃ
ব্যাকটেরিয়ার বংশবৃদ্ধির জন্য দরকার খাবার। কালচার মিডিয়া হল সেই খাবার। অন্যন্য পুষ্টিউপাদানের সঙ্গে জিলাটিনে আছে প্রায় সবধরনের এমিনো এসিড। মানুষ যেমন সবগুলি এমিনো এসিড নিজের দেহে তৈরি করতে পারেনা, বাইরে থেকে নিতে হয়, তেমনি ব্যাকটেরিয়াও পারেনা। কিন্তু আগার আগারে এতগুলো এমিনো এসিড সাধারনত পাওয়া যায়না বলে সঙ্গে গরুর মাংসের ব্রথ দেয়া হয়। সঙ্গে চিনি হলো শর্করার উৎস।
পাত্র এবং আগার দ্রবণ গরম করার কারন হল স্টেরিলাইজেশান বা জীবাণুমুক্ত করা।
মানুষের শরীরে যতটি কোষ আছে তার ১০০০ গুন বেশি আছে বিভিন্ন রকমের অণুজীব, যার মধ্যে প্রায় সবই বিভিন্ন রকমের ব্যাকটেরিয়া। এদের আমরা দেখতে পাইনা খালিচোখে। কিন্তু এদেরকে খাবার দেয়া হলে ব্যাকটেরিয়াগুলি যখন অনেকগুলো একটা যায়গায় বংশবৃদ্ধি করে তখন খালি চোখেই। যেটা দেখতে পাই সেটাকে বলে কলোনী। কালচার মিডিয়াতে একটি গোল বিন্দু হল একটা ব্যাকটেরিয়া থেকে তৈরি ব্যাকটেরিয়ার কলোনী, যেখানে সব ব্যাকটেরিয়া একে অপরের আত্মীয় এবং একই রকম। জিনগত এবং বাহি্যকভাবেও। কলোনীর আকার, গঠন এবং রঙ একটি নির্দিষ্ট মিডিয়াতে (মিডিয়া অনেক ধরনের হতে পারে) ব্যাকটেরিয়া ভেদে একেকরকম হয়ঃ

মনে রাখবেন, ব্যাকটেরিয়ার সঙ্গে সঙ্গে ছত্রাকও দেখতে পারেন আপনার কালচারে। নিচের ছবি দেখে মিলিয়ে নিন কোনটা ব্যাকটেরিয়া কলোনি আর কোনটা ছত্রাক। ছত্রাক দেখতে একটু তুলা তুলা টাইপের।

শরীরের একেক অংশের ব্যাকটেরিয়ার কলোনীগুলে সংখ্যায় এবং দেখতে একেকরকম হওয়ার কথা। নিজের শরীরেরটা পরীক্ষা করে ফেলুন না!

Leave a Reply